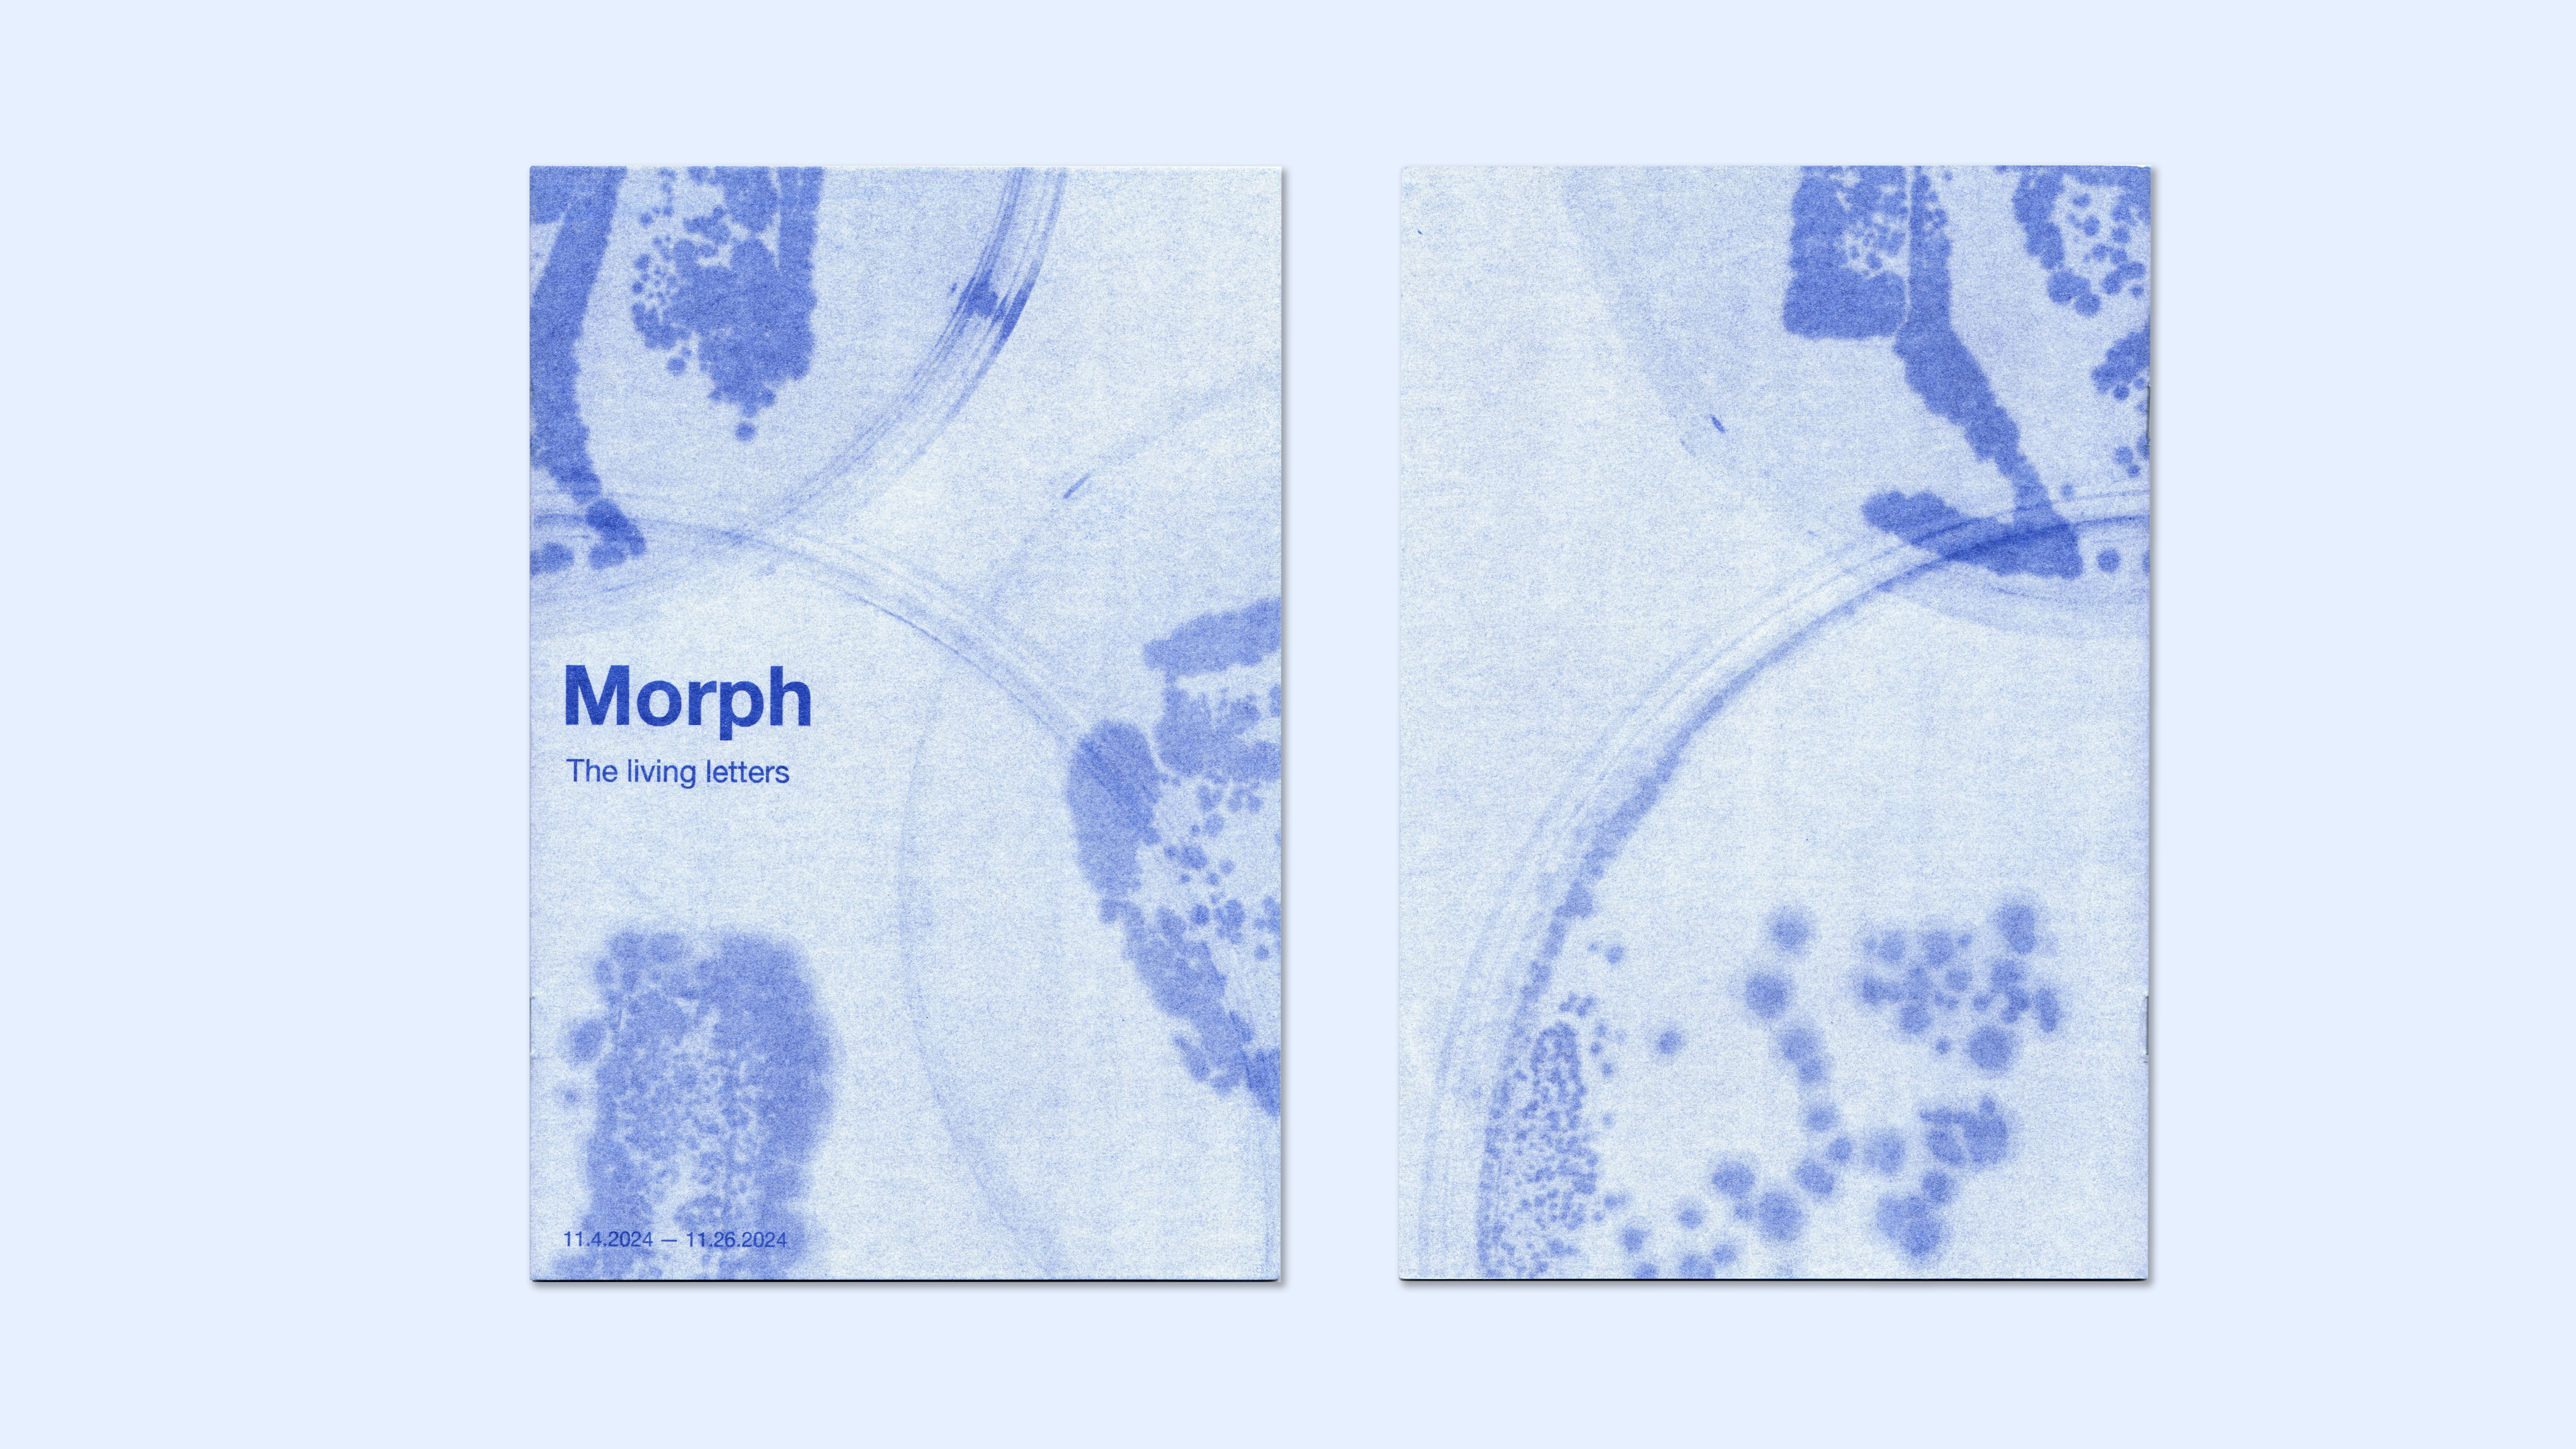
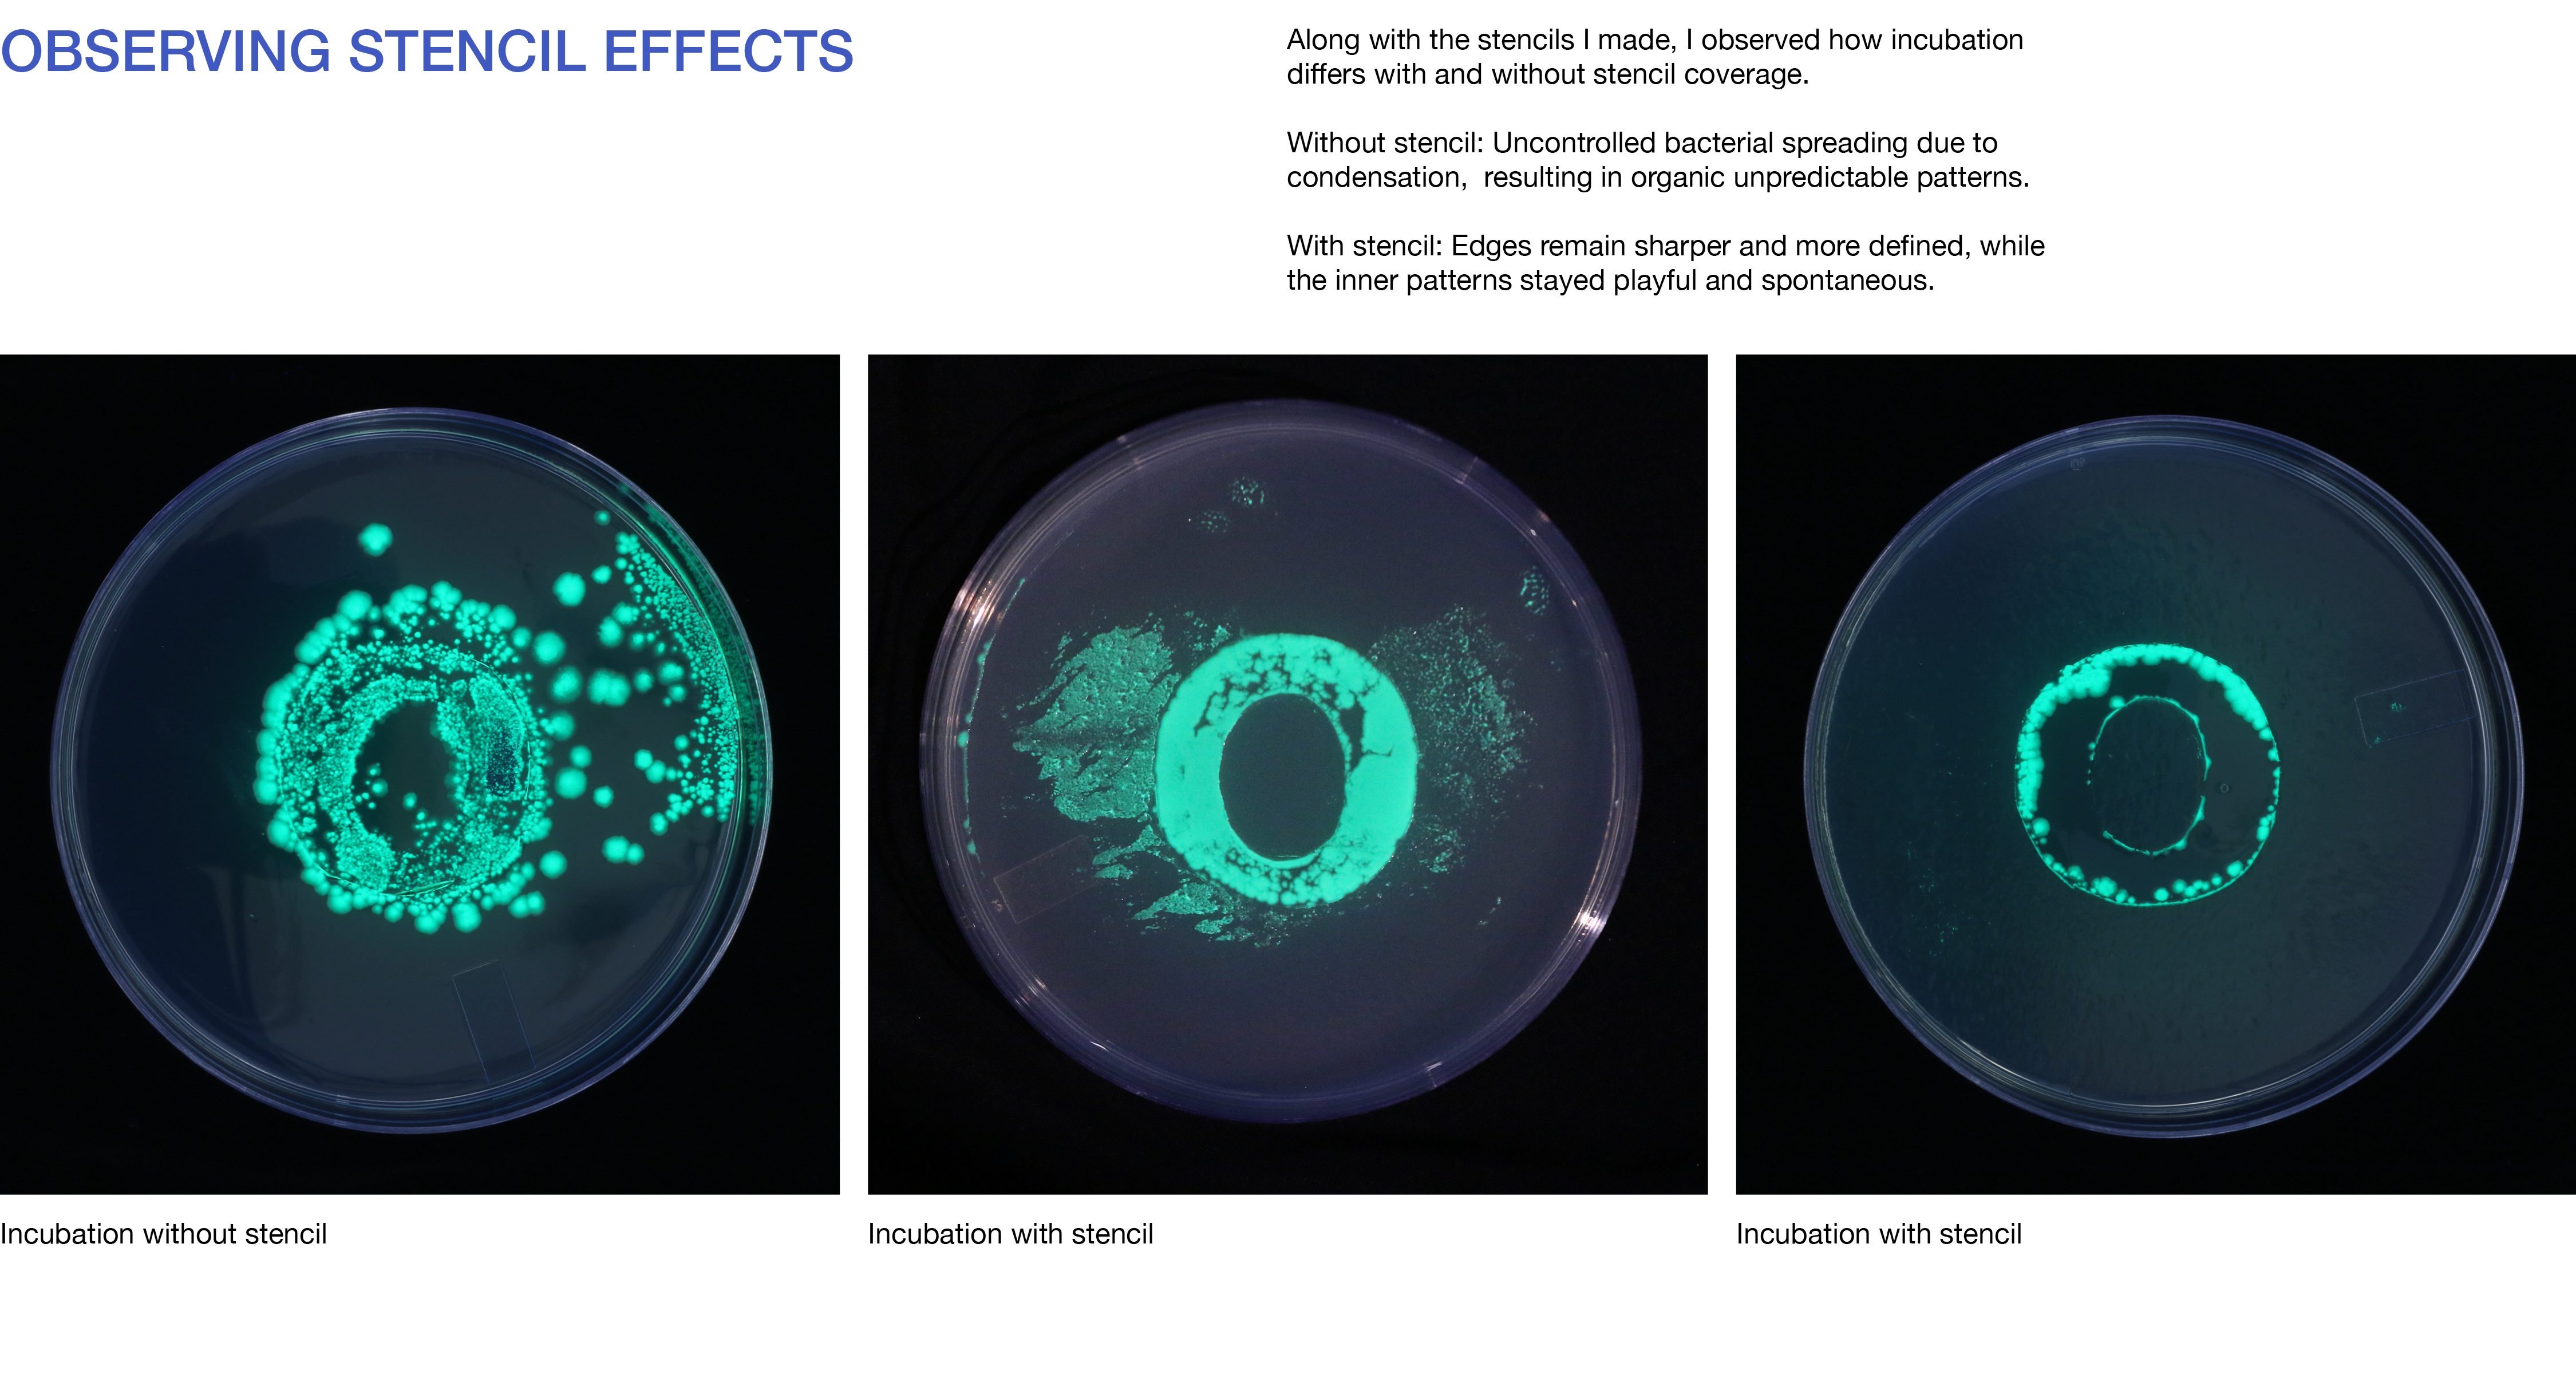
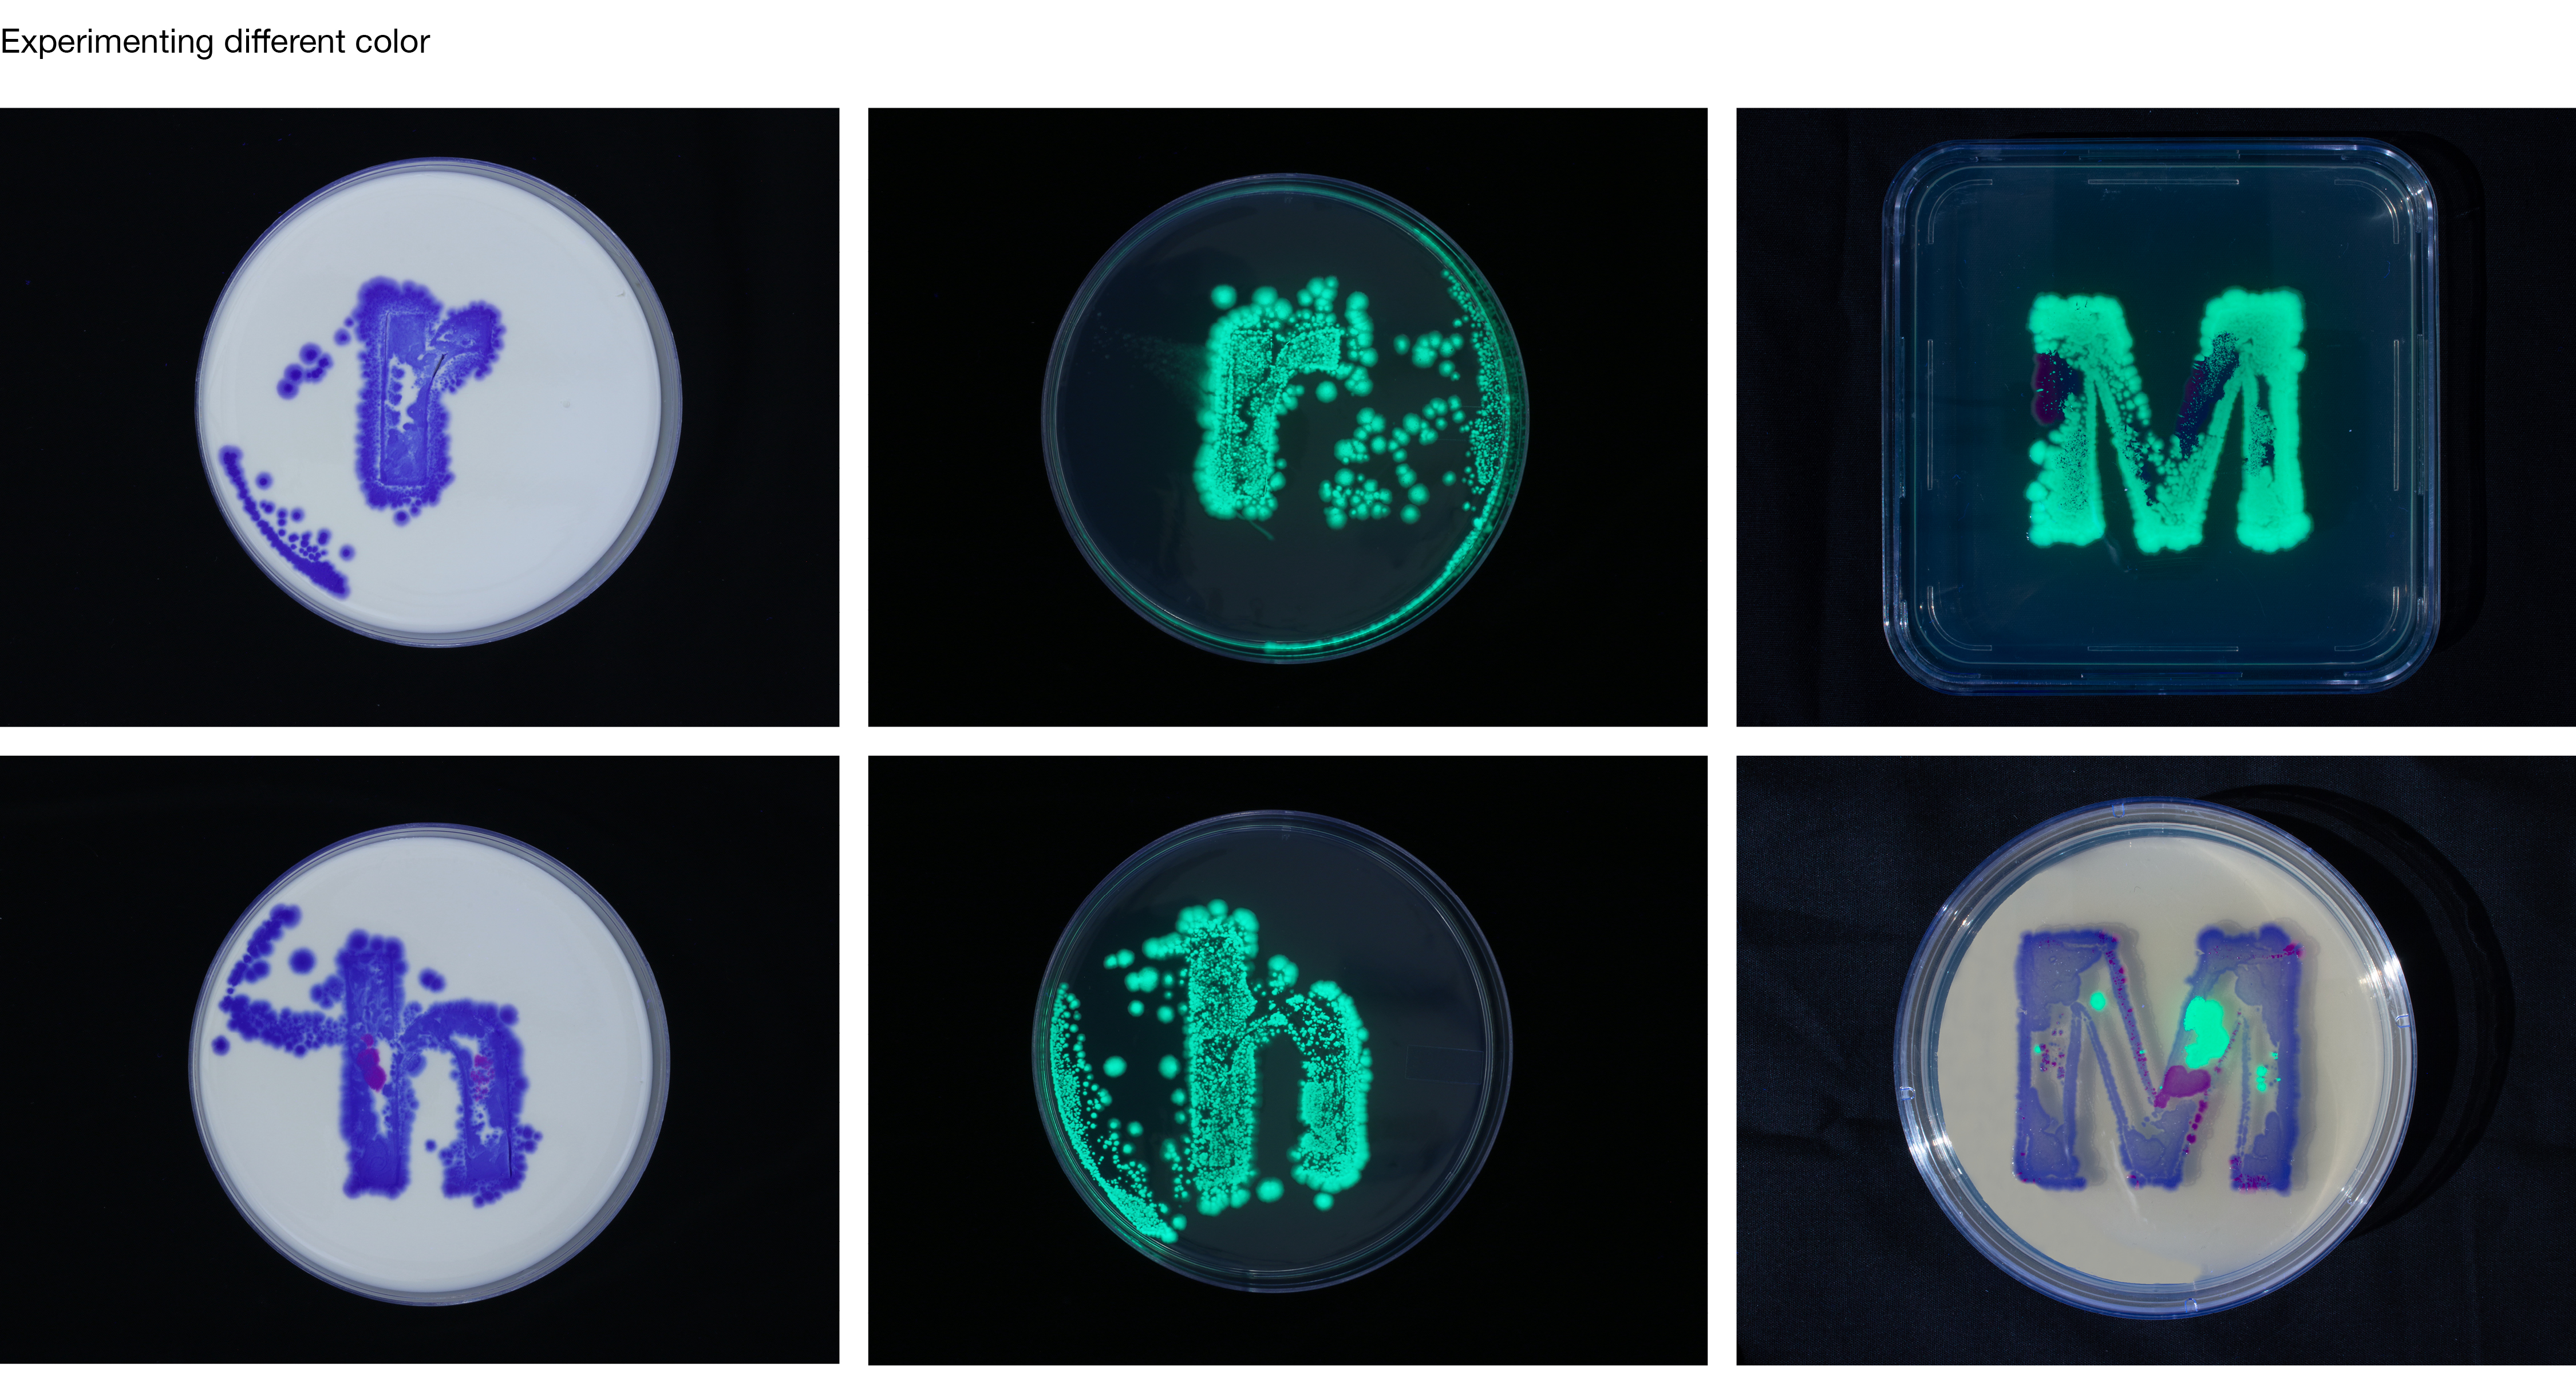
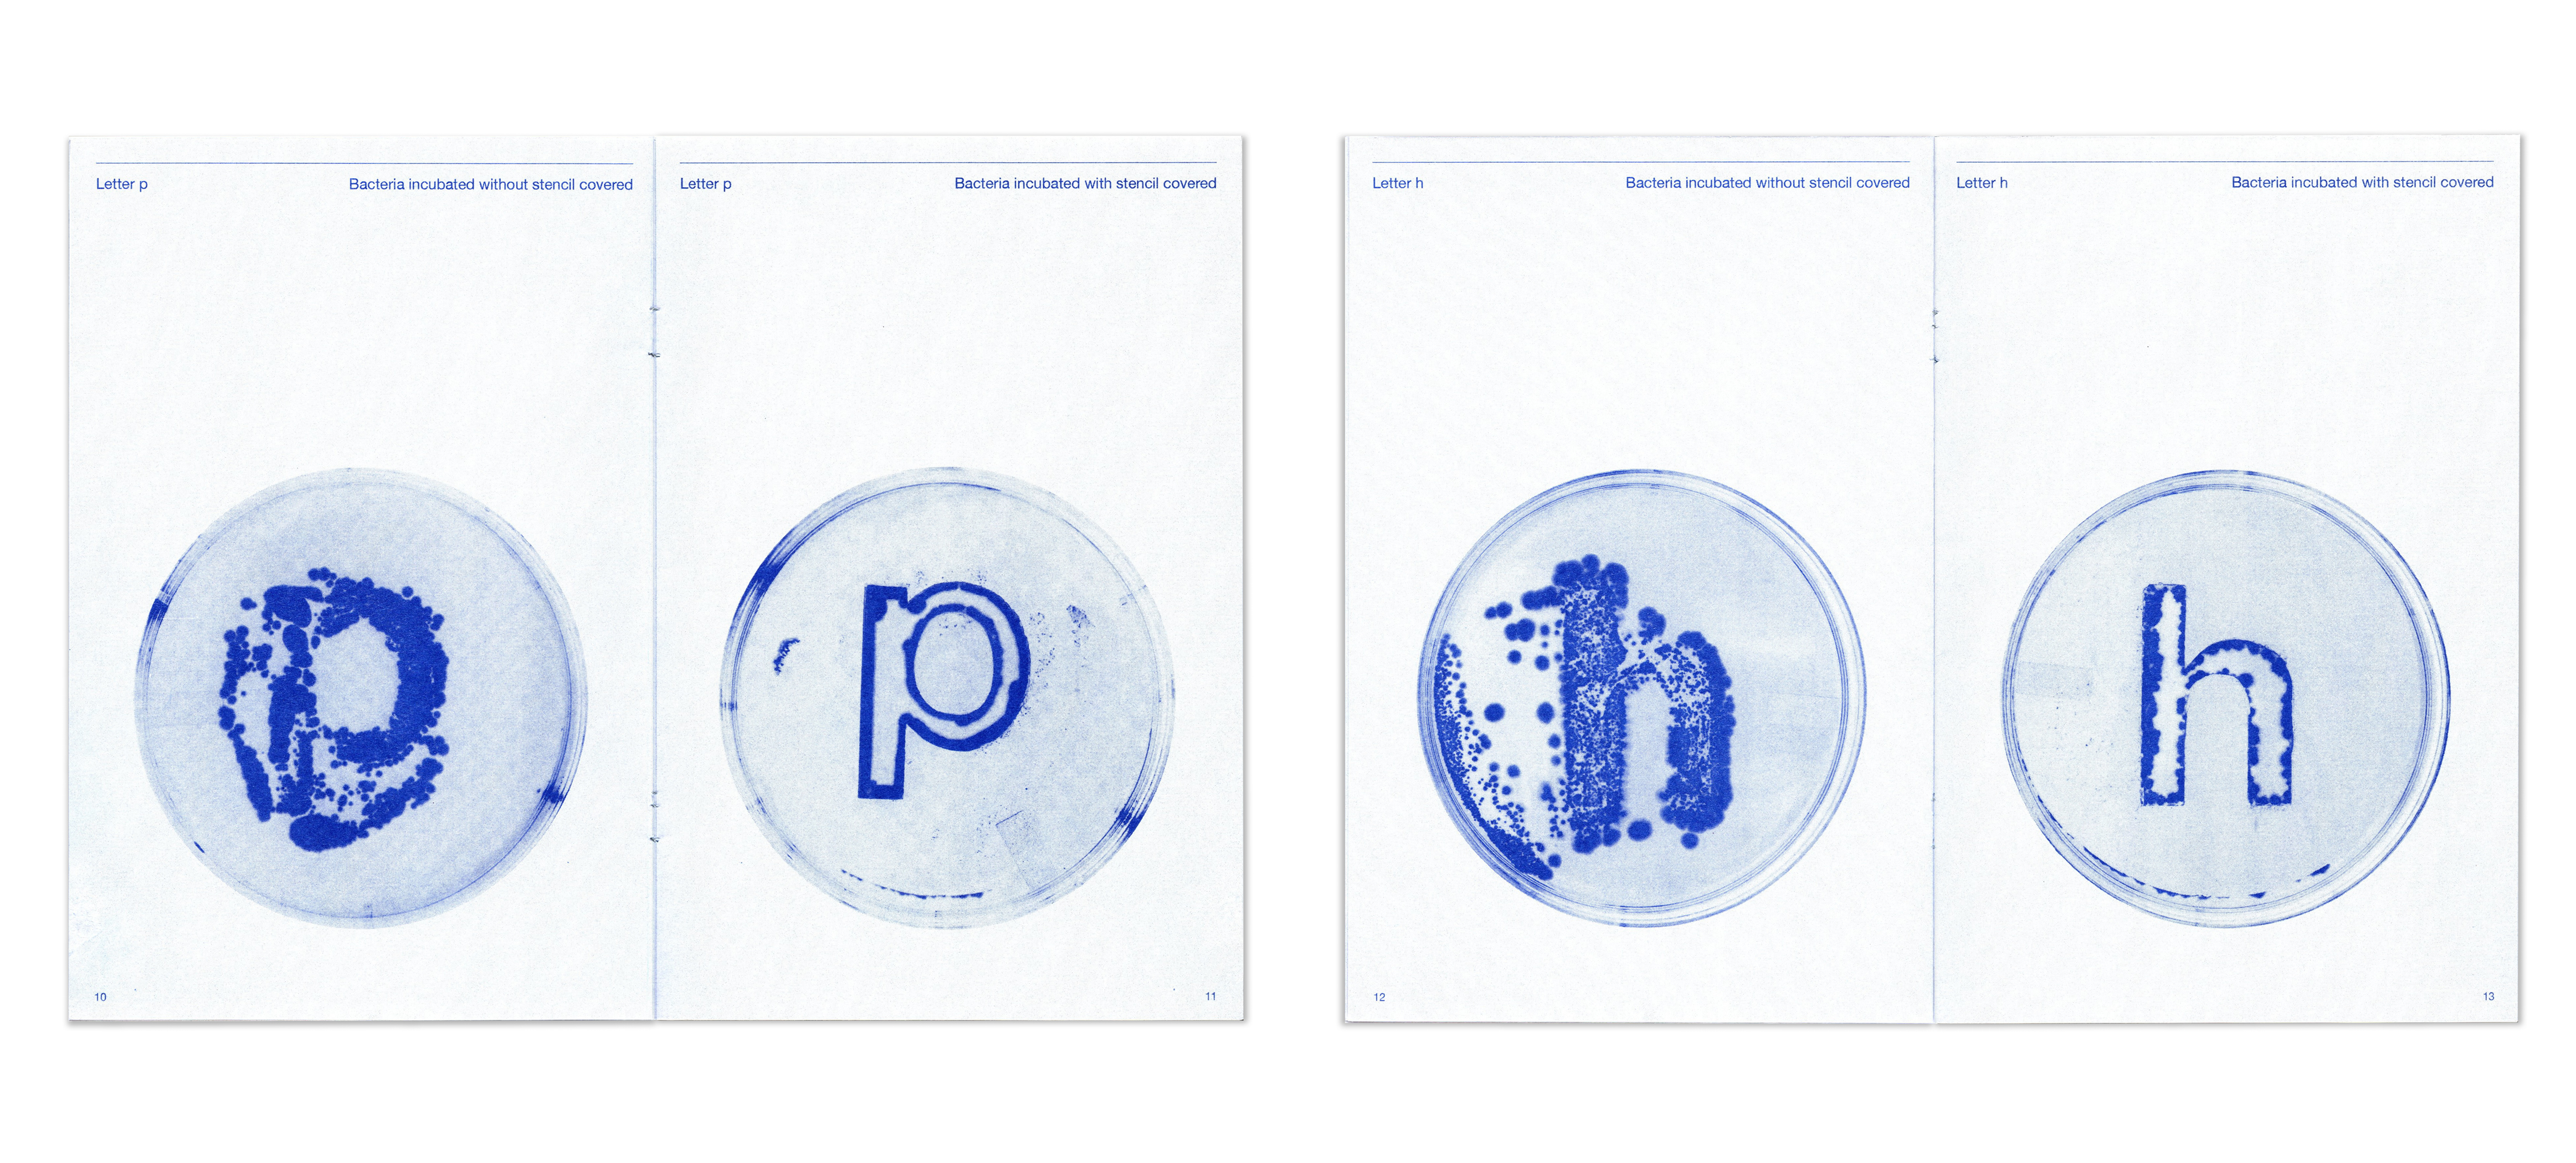

Morph: The living letters
Bio Art, Bacteria painting, Type design / 2025
Bio Art, Bacteria painting, Type design / 2025
While technological advancements have made everything increasingly precise and static, I find inspiration in the unpredictability of using bacteria in printmaking. This process introduces a living, evolving quality that brings emotional depth to both language and form. My exploration focused on cultivating bacterial growth through the practice of bacteria painting, observing how letterforms emerged, shifted, and transformed over time. I documented the process through a series of experimental prints and compiled the outcomes into a risograph-printed zine.

Other spreads︎︎︎